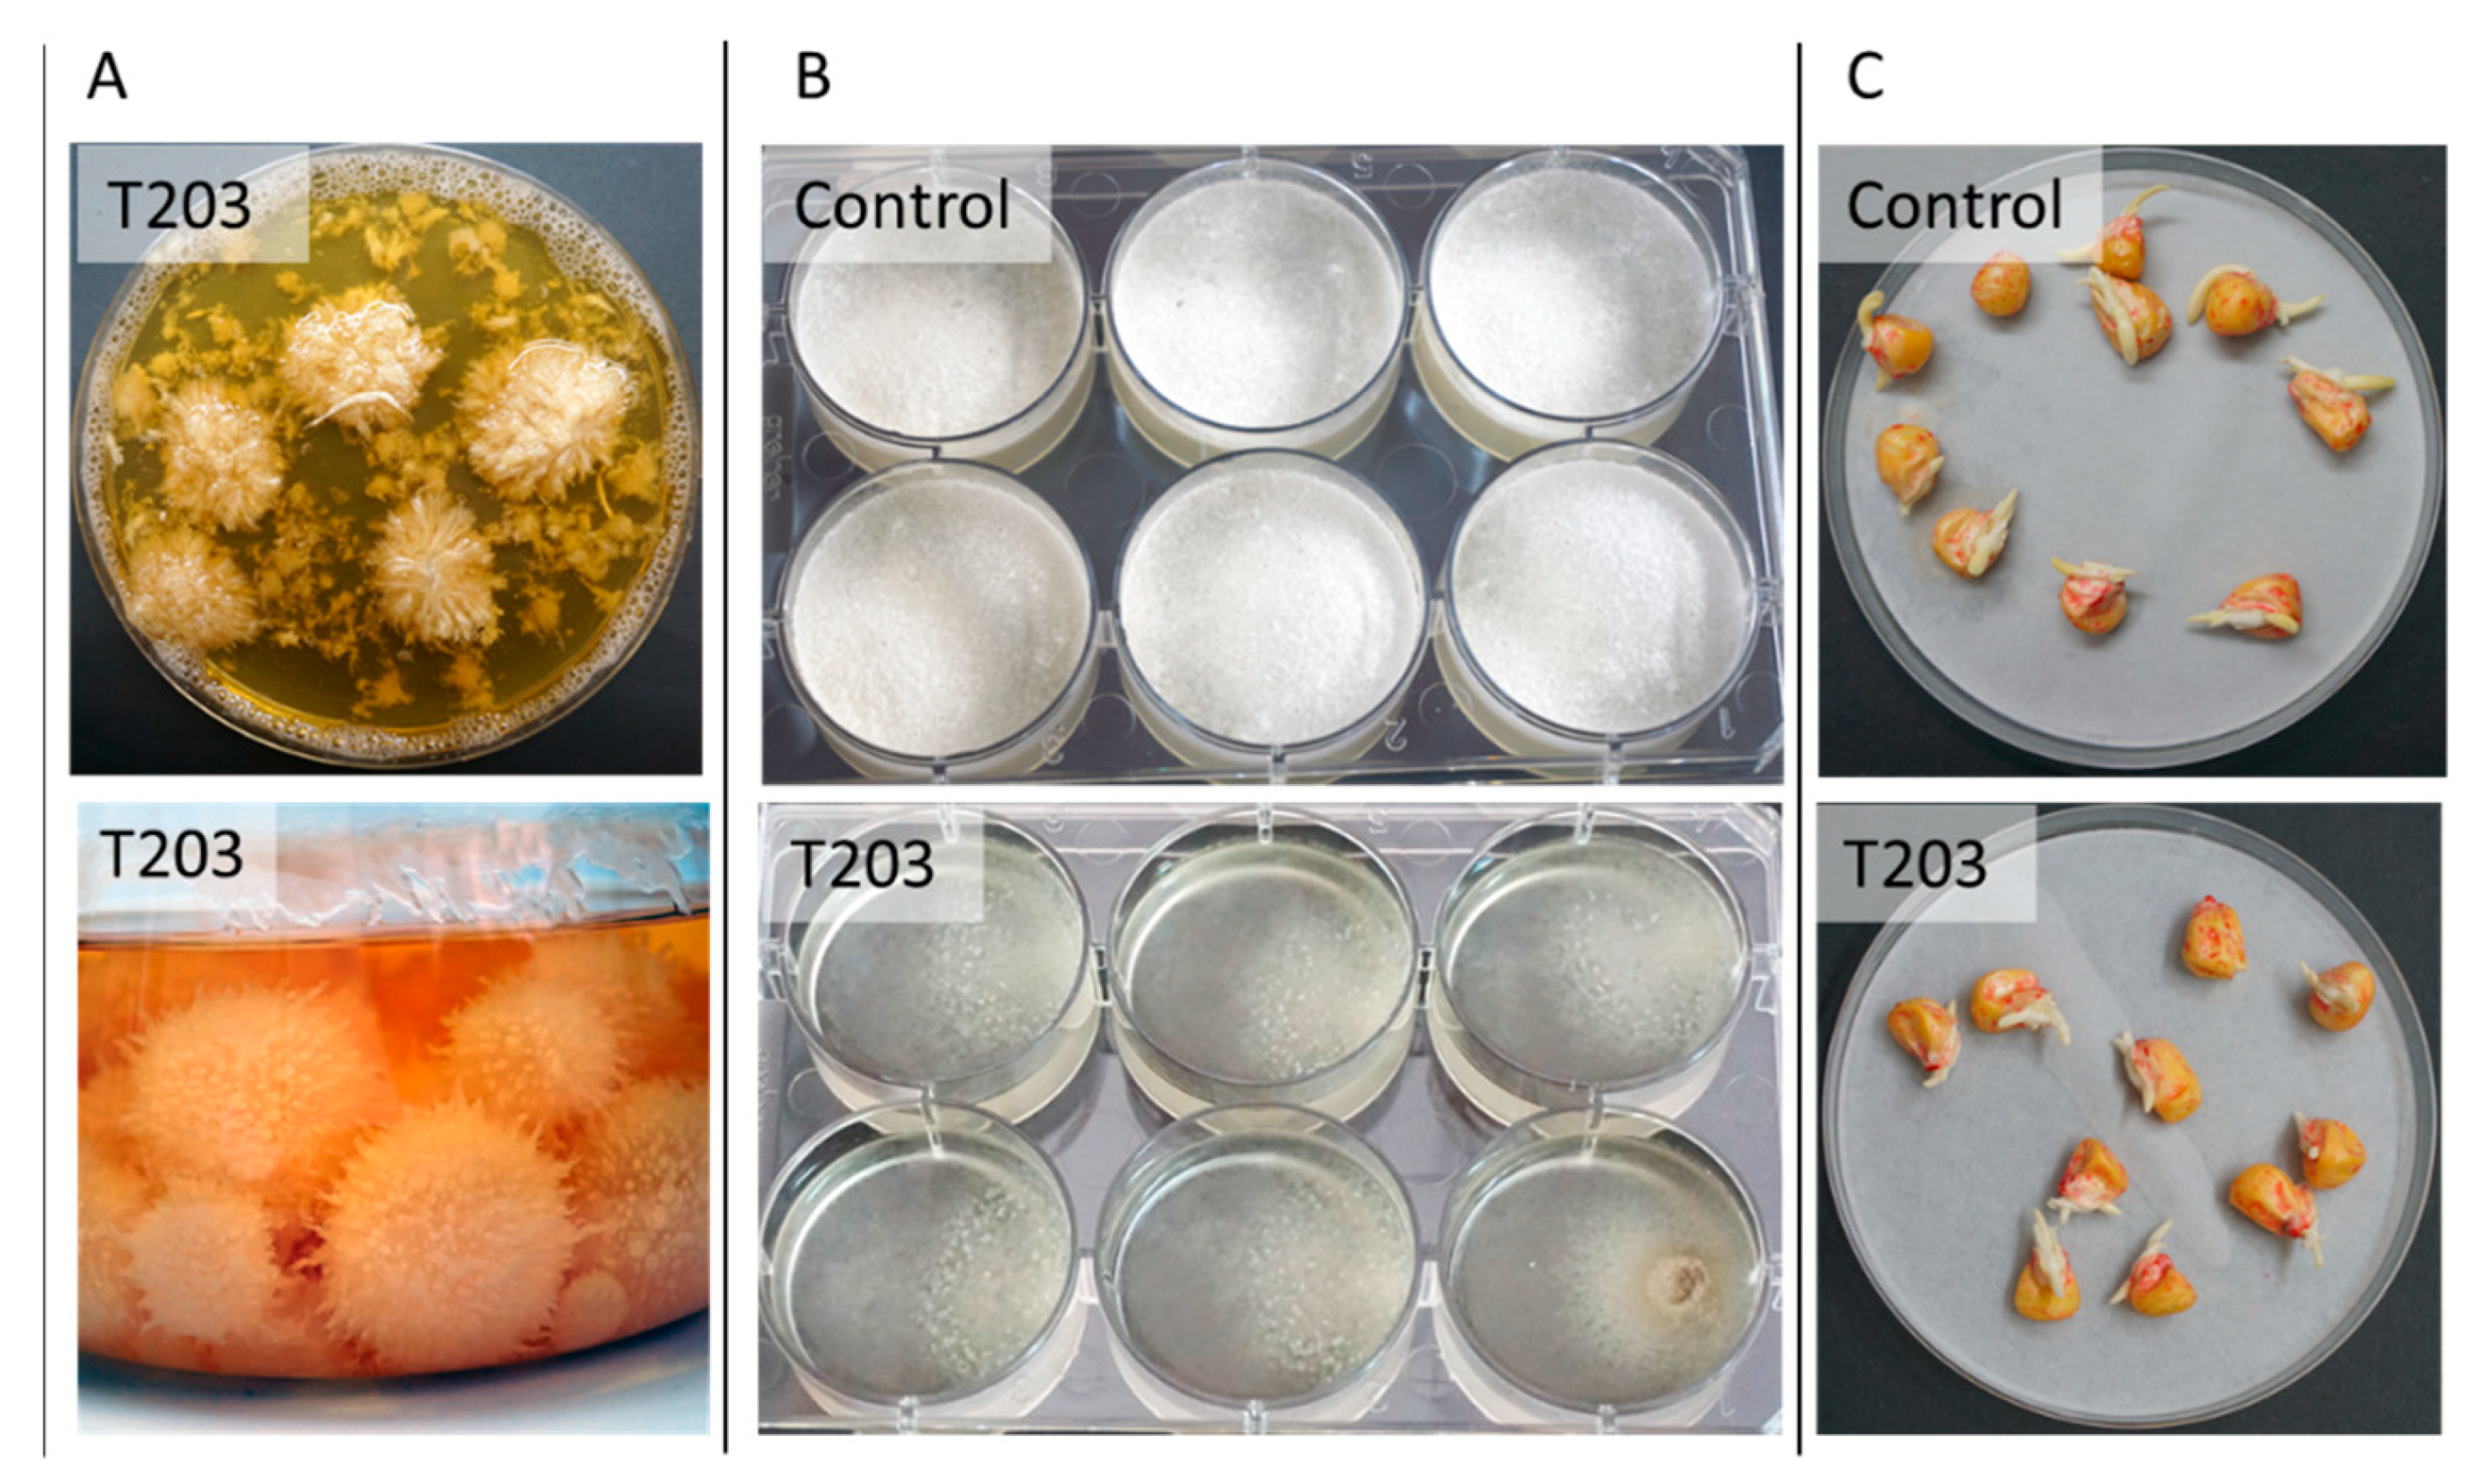
Pathogens 11 00013 g007

Control Strategies to Cope with Late Wilt of Maize
Abstract
:1. Introduction
2. Late Wilt Disease
2.1. The Pathogen
2.2. Geographic Distribution
2.3. Disease Cycle and Pathogenesis
2.4. Disease Symptoms
3. Control Strategies
3.1. Host Resistance
3.2. Chemical Control
3.2.1. From In Vitro Evaluation to a Field Assay of Selected Fungicides
3.2.2. Seed Coating
3.2.3. Soil Treatments
3.2.4. Azoxystrobin Irrigation-Based Treatments
3.2.5. Fungicide Resistance
3.3. Biological Control
3.3.1. Strengthening Beneficial Microorganism Communities in the Soil and Their Secreted Metabolites
3.3.2. Trichoderma spp. Maize Late Wilt Biocontrol
3.3.3. Manipulating the Plant Microbiome
3.4. Agrotechnical Measures
3.4.1. Various Cultural Methods
3.4.2. Beneficial Mycorrhizal Communities
4. Future Challenges and Opportunities
Funding
Institutional Review Board Statement
Informed Consent Statement
Data Availability Statement
Acknowledgments
Conflicts of Interest
References
- Gálvez Ranilla, L. The Application of Metabolomics for the Study of Cereal Corn (Zea mays L.). Metabolites 2020, 10, 300. [Google Scholar] [CrossRef] [PubMed]
- Ray, D.K.; Mueller, N.D.; West, P.C.; Foley, J.A. Yield trends are insufficient to double global crop production by 2050. PLoS ONE 2013, 8, e66428. [Google Scholar] [CrossRef] [PubMed] [Green Version]
- Mueller, D.S.; Wise, K.A.; Sisson, A.J.; Allen, T.W.; Bergstrom, G.C.; Bissonnette, K.M.; Bradley, C.A.; Byamukama, E.; Chilvers, M.I.; Collins, A.A. Corn yield loss estimates due to diseases in the united states and ontario, canada, from 2016 to 2019. Plant Health Prog. 2020, 21, 238–247. [Google Scholar] [CrossRef]
- Pratap, A.; Kumar, J. Alien Gene Transfer in Crop Plants, Volume 2: Achievements and Impacts; Springer: New York, NY, USA, 2014; Volume 2. [Google Scholar] [CrossRef]
- El-Naggarr, A.A.A.; Sabryr, A.M.; Yassin, M.A. Impact of late wilt disease caused by Harpophora maydis on maize yield. J. Biol. Chem. Environ. Soc. 2015, 10, 577–595. [Google Scholar]
- Degani, O.; Cernica, G. Diagnosis and Control of Harpophora maydis, the Cause of Late Wilt in Maize. Adv. Microbiol. 2014, 4, 94–105. [Google Scholar] [CrossRef] [Green Version]
- Sunitha, N.; Gangappa, E.; Gowda, R.V.; Ramesh, S.; Biradar, S.; Swamy, D.; Hemareddy, H. Assessment of Impact of Late Wilt Caused by Harpophora maydis (Samra, Sabet and Hing) on Grain Yield and its Attributing Traits in Maize (Zea mays L.). Mysore J. Agric. Sci. 2020, 54, 30–36. [Google Scholar]
- Ortiz-Bustos, C.M.; Testi, L.; García-Carneros, A.B.; Molinero-Ruiz, L. Geographic distribution and aggressiveness of Harpophora maydis in the Iberian peninsula, and thermal detection of maize late wilt. Eur. J. Plant Pathol. 2015, 144, 383–397. [Google Scholar] [CrossRef]
- Samra, A.; Sabet, K.; Kamel, M.; Abd El-Rahim, M. Further Studies on the Effect of Field Conditions and Cultural Practices on Infection with Stalk-Rot Complex of Maize; Arab Republic of Egypt, Min. of Agriculture, Plant Protection Department: Hanoi, Viet Nam, 1971.
- Degani, O.; Movshowitz, D.; Dor, S.; Meerson, A.; Goldblat, Y.; Rabinovitz, O. Evaluating Azoxystrobin Seed Coating Against Maize Late Wilt Disease Using a Sensitive qPCR-Based Method. Plant Dis. 2019, 103, 238–248. [Google Scholar] [CrossRef] [Green Version]
- Drori, R.; Sharon, A.; Goldberg, D.; Rabinovitz, O.; Levy, M.; Degani, O. Molecular diagnosis for Harpophora maydis, the cause of maize late wilt in Israel. Phytopathol. Mediterr. 2013, 52, 16–29. [Google Scholar]
- Payak, M.; Sharma, R. Research on Diseases of Maize; Indian Council of Agricultural Research: New Delhi, India, 1978; p. 228. [Google Scholar]
- Johal, L.; Huber, D.M.; Martyn, R. Late wilt of corn (maize) pathway analysis: Intentional introduction of Cephalosporium maydis. In Pathways Analysis for the Introduction to the U.S. of Plant Pathogens of Economic Importance; Purdue University: West Lafayette, IN, USA, 2004. [Google Scholar]
- Bergstrom, G.; Leslie, F.J.; Huber, D.; Lipps, P.; Warren, H.; Esker, P.; Grau, C.; Botratynski, T.; Bulluck, R.; Floyd, J.; et al. Recovery Plan For Late Wilt of Corn Caused by Harpophora maydis Syn. Cephalosporium maydis; National Plant Disease Recovery System (NPDRS): Washington, DC, USA, 2008; p. 24.
- Samra, A.S.; Sabet, K.A.; Hingorani, M.K. A new wilt disease of maize in Egypt. Plant Dis. Rep. 1962, 46, 481–483. [Google Scholar]
- Degani, O.; Dor, S.; Movshovitz, D.; Rabinovitz, O. Methods for Studying Magnaporthiopsis maydis, the Maize Late Wilt Causal Agent. Agronomy 2019, 9, 181. [Google Scholar] [CrossRef] [Green Version]
- Degani, O. A Review: Late Wilt of Maize—The Pathogen, the Disease, Current Status and Future Perspective. J. Fungi 2021, 7, 989. [Google Scholar] [CrossRef] [PubMed]
- Samra, A.S.; Sabet, K.A.; Abdel-Rahim, M.F. Effect of Soil Conditions and Cultural Practices on Infection with Stalk Rots; U.A.R. Ministry of Agric. Government Printing Offices: Cairo, Egypt, 1966; pp. 117–164.
- Singh, S.D.; Siradhana, B.S. Effect of macro and micronutrients on the development of late wilt of maize induced by Cephalosporium maydis. Summa Phytopath 1990, 16, 140–145. [Google Scholar]
- Elshahawy, I.E.; El-Sayed, A.E.-K.B. Maximizing the efficacy of Trichoderma to control Cephalosporium maydis, causing maize late wilt disease, using freshwater microalgae extracts. Egypt. J. Biol. Pest Control 2018, 28, 48. [Google Scholar] [CrossRef] [Green Version]
- Fayzalla, E.; Sadik, E.; Elwakil, M.; Gomah, A. Soil solarization for controlling Cephalosporium maydis, the cause of late wilt disease of maize in Egypt. Egypt J. Phytopathol. 1994, 22, 171–178. [Google Scholar]
- Tej, R.; Rodríguez-Mallol, C.; Rodríguez-Arcos, R.; Karray-Bouraoui, N.; Molinero-Ruiz, L. Inhibitory effect of Lycium europaeum extracts on phytopathogenic soil-borne fungi and the reduction of late wilt in maize. Eur. J. Plant Pathol. 2018, 152, 249–265. [Google Scholar] [CrossRef] [Green Version]
- Abd-el-Rahim, M.F.; Sabet, K.A.; El-Shafey, H.A.; El-Assiuty, E.M. Chemical control of the late-wilt disease of maize caused by Cephalosporium maydis. Agric. Res. Rev. 1982, 60, 31–49. [Google Scholar]
- Degani, O.; Weinberg, T.; Graph, S. Chemical control of maize late wilt in the field. Phytoparasitica 2014, 42, 559–570. [Google Scholar] [CrossRef]
- Patanita, M.; Campos, M.D.; Félix, M.d.R.; Carvalho, M.; Brito, I. Effect of Tillage System and Cover Crop on Maize Mycorrhization and Presence of Magnaporthiopsis maydis. Biology 2020, 9, 46. [Google Scholar] [CrossRef] [Green Version]
- Degani, O.; Gordani, A.; Becher, P.; Dor, S. Crop Cycle and Tillage Role in the Outbreak of Late Wilt Disease of Maize Caused by Magnaporthiopsis maydis. J. Fungi 2021, 7, 706. [Google Scholar] [CrossRef]
- Degani, O.; Dor, S.; Chen, A.; Orlov-Levin, V.; Stolov-Yosef, A.; Regev, D.; Rabinovitz, O. Molecular Tracking and Remote Sensing to Evaluate New Chemical Treatments Against the Maize Late Wilt Disease Causal Agent, Magnaporthiopsis maydis. J. Fungi 2020, 6, 54. [Google Scholar] [CrossRef]
- Degani, O.; Dor, S.; Movshowitz, D.; Fraidman, E.; Rabinovitz, O.; Graph, S. Effective chemical protection against the maize late wilt causal agent, Harpophora maydis, in the field. PLoS ONE 2018, 13, e0208353. [Google Scholar] [CrossRef] [PubMed]
- Massi, F.; Torriani, S.F.; Borghi, L.; Toffolatti, S.L. Fungicide Resistance Evolution and Detection in Plant Pathogens: Plasmopara viticola as a Case Study. Microorganisms 2021, 9, 119. [Google Scholar] [CrossRef] [PubMed]
- Ons, L.; Bylemans, D.; Thevissen, K.; Cammue, B.P.A. Combining Biocontrol Agents with Chemical Fungicides for Integrated Plant Fungal Disease Control. Microorganisms 2020, 8, 1930. [Google Scholar] [CrossRef] [PubMed]
- Ghazy, N.; El-Nahrawy, S. Siderophore production by Bacillus subtilis MF497446 and Pseudomonas koreensis MG209738 and their efficacy in controlling Cephalosporium maydis in maize plant. Arch. Microbiol. 2020. [Google Scholar] [CrossRef]
- Sood, M.; Kapoor, D.; Kumar, V.; Sheteiwy, M.S.; Ramakrishnan, M.; Landi, M.; Araniti, F.; Sharma, A. Trichoderma: The “secrets” of a multitalented biocontrol agent. Plants 2020, 9, 762. [Google Scholar] [CrossRef] [PubMed]
- Gazala, P.; Gangappa, E.; Ramesh, S.; Swamy, D. Comparative Breeding potential of two crosses for response to late wilt disease (LWD) in maize (Zea mays L.). Genet. Resour. Crop Evol. 2021, 68, 1751–1757. [Google Scholar] [CrossRef]
- Rakesh, B.; Gangappa, E.; Sonali, G.; Gowda, R.P.V.; Swamy, S.D.; Ramesh, S.; Hemareddy, H.B.; Nagaraju, N. Modified method of screening maize inbred lines to late wilt disease caused by Harpophora maydis. Mysore J. Agric. Sci. 2016, 50, 684–690. [Google Scholar]
- Agag, S.H.; Sabry, A.M.; EL-Samman, M.G.; Mostafa, M.H. Pathological and Molecular Characterization of Magnaporthiopsis maydis Isolates Causing Late Wilt in Maize. Egypt. J. Phytopathol. 2021, 49, 1–9. [Google Scholar] [CrossRef]
- Zeller, K.A.; Ismael, A.M.; El-Assiuty, E.M.; Fahmy, Z.M.; Bekheet, F.M.; Leslie, J.F. Relative Competitiveness and Virulence of Four Clonal Lineages of Cephalosporium maydis from Egypt Toward Greenhouse-Grown Maize. Plant Dis. 2002, 86, 373–378. [Google Scholar] [CrossRef] [PubMed] [Green Version]
- Michail, S.H.; Abou-Elseoud, M.S.; Nour Eldin, M.S. Seed health testing of corn for Cephalosporium maydis. Acta Phytopathol. Entomol. Hung. 1999, 34, 35–42. [Google Scholar]
- Sabet, K.A.; Zaher, A.M.; Samra, A.S.; Mansour, I.M. Pathogenic behaviour of Cephalosporium maydis and C. acremonium. Ann. Appl. Biol. 1970, 66, 257–263. [Google Scholar] [CrossRef]
- Klaubauf, S.; Tharreau, D.; Fournier, E.; Groenewald, J.Z.; Crous, P.W.; de Vries, R.P.; Lebrun, M.H. Resolving the polyphyletic nature of Pyricularia (Pyriculariaceae). Stud. Mycol. 2014, 79, 85–120. [Google Scholar] [CrossRef]
- Luo, J.; Zhang, N. Magnaporthiopsis, a new genus in Magnaporthaceae (Ascomycota). Mycologia 2013, 105, 1019–1029. [Google Scholar] [CrossRef]
- Samra, A.S.; Sabet, K.A.; Hingorani, M.K. Late wilt disease of maize caused by Cephalosporium maydis. Phytopathology 1963, 53, 402–406. [Google Scholar]
- Gams, W. Phialophora and some similar morphologically little-differentiated anamorphs of divergent ascomycetes. Stud. Mycol. 2000, 45, 187–200. [Google Scholar]
- Zeller, K.A.; Jurgenson, J.E.; El-Assiuty, E.M.; Leslie, J.F. Isozyme and amplified fragment length polymorphisms from Cephalosporium maydis in Egypt. Phytoparasitica 2000, 28, 121–130. [Google Scholar] [CrossRef]
- Sahab, A.F.; Osman, A.R.; Soleman, N.K.; Mikhail, M.S. Studies on root-rot of lupin in Egypt and its control. Egypt. J. Phytopathol. 1985, 17, 23–35. [Google Scholar]
- Degani, O.; Dor, S.; Abraham, D.; Cohen, R. Interactions between Magnaporthiopsis maydis and Macrophomina phaseolina, the Causes of Wilt Diseases in Maize and Cotton. Microorganisms 2020, 8, 249. [Google Scholar] [CrossRef] [PubMed] [Green Version]
- Sabet, K.; Samra, A.; Mansour, I. Interaction between Fusarium oxysporum f. vasinfectum and Cephalosporium maydis on cotton and maize. Ann. Appl. Biol. 1966, 58, 93–101. [Google Scholar] [CrossRef]
- Dor, S.; Degani, O. Uncovering the Host Range for Maize Pathogen Magnaporthiopsis maydis. Plants 2019, 8, 259. [Google Scholar] [CrossRef] [Green Version]
- Sabet, K.A.; Samra, A.S.; Hingorani, M.K.; Mansour, I.M. Stalk and root rots of maize in the United Arab Republic. FAO Plant Prot. Bull. 1961, 9, 121–125. [Google Scholar]
- Payak, M.M.; Lal, S.; Lilaramani, J.; Renfro, B.L. Cephalosporium maydis—A new threat to maize in India. Indian Phytopathol. 1970, 23, 562–569. [Google Scholar]
- Pecsi, S.; Nemeth, L. Appearance of Cephalosporium maydis Samra Sabet and Hingorani in Hungary. Mededelingen Faculteit Landbouwkundige en Toegepaste Biologische Wetenschappen. Univ. Gent. Ghent Belgium 1998, 63, 873–877. [Google Scholar]
- Molinero-Ruiz, M.L.; Melero-Vara, J.M.; Mateos, A. Cephalosporium maydis, the cause of late wilt in maize, a pathogen new to Portugal and Spain. Plant Dis. 2011, 94, 379. [Google Scholar] [CrossRef] [PubMed] [Green Version]
- Subedi, S. A review on important maize diseases and their management in Nepal. J. Maize Res. Dev. 2015, 1, 28–52. [Google Scholar] [CrossRef]
- Veerabhadraswamy, A.; Garampalli, R.H. Effect of arbuscular mycorrhizal fungi in the management of black bundle disease of maize caused by Cephalosporium acremonium. Sci. Res. Rep. 2011, 1, 96–100. [Google Scholar]
- Mohamed, H.A.; Moneim, A.; Fathi, S. Reaction of corn inbred lines, varieties, and hybrids to four fungi causing stalk rots. Plant Dis. Rep. 1966, 50, 401–402. [Google Scholar]
- Sabet, K.; Samra, A.; Abd-el-Rahim, M. Seed Transmission of Stalk-Rot Fungi and Effect of Seed Treatment. In Investigations on Stalk-Rot Disease of Maize in UAR; Ministry of Agriculture, Government Printing Offices: Cairo, Egypt, 1966. [Google Scholar]
- Ortiz-Bustos, C.; López-Bernal, A.; Testi, L.; Molinero-Ruiz, L. Environmental and irrigation conditions can mask the effect of Magnaporthiopsis maydis on growth and productivity of maize. Plant Pathol. 2019. [Google Scholar] [CrossRef]
- Degani, O.; Goldblat, Y. Ambient Stresses Regulate the Development of the Maize Late Wilt Causing Agent, Harpophora maydis. Agric. Sci. 2014, 5, 571–582. [Google Scholar] [CrossRef] [Green Version]
- Degani, O.; Rabinovitz, O.; Becher, P.; Gordani, A.; Chen, A. Trichoderma longibrachiatum and Trichoderma asperellum Confer Growth Promotion and Protection against Late Wilt Disease in the Field. J. Fungi 2021, 7, 444. [Google Scholar] [CrossRef] [PubMed]
- Degani, O.; Regev, D.; Dor, S.; Rabinovitz, O. Soil Bioassay for Detecting Magnaporthiopsis maydis Infestation Using a Hyper Susceptible Maize Hybrid. J. Fungi 2020, 6, 107. [Google Scholar] [CrossRef]
- Sabet, K.A.; Samra, A.S.; Mansour, I.M. Late-Wilt disease of maize and a study of the causal organism. In Investigations on Stalk-Rot Disease of Maize in U.A.R. (Egypt); Ministry of Agriculture Editing, Publication and Bibliography Control: Washington, DC, USA, 1966; pp. 8–45. [Google Scholar]
- Abd El-Rahim, M.F.; Fahmy, G.M.; Fahmy, Z.M. Alterations in transpiration and stem vascular tissues of two maize cultivars under conditions of water stress and late wilt disease. Plant Pathol. 1998, 47, 216–223. [Google Scholar] [CrossRef]
- Farahat, G.A.; Barakat, E.H.; El-Bana, M. Effects of late wilt disease on infection development of ear rot disease, phenolic compounds, trypsin and α-amylase inhibitors of some maize hybrids grains and quality characteristics of fortified cookies. Middle East J. Agric. Res. 2020, 9, 515–532. [Google Scholar]
- Shehata, F.A. The Inheritance of Resistence to Late Wilt Caused by Cephalosporium maydis in Some Corn Lines. Master’s Thesis, Al-Azhar University, Cairo, Egypt, 1976. [Google Scholar]
- Shalaby, M.; El-Moghazy, S.; Mehesen, A.A. Biological control of maize late wilt disease caused by Cephalosporium maydis. J. Agric. Res. Kafrelsheikh Univ. 2009, 35, 1–19. [Google Scholar]
- Sunitha, N.; Gangappa, E.; GOWDA, R.V.; Ramesh, S.; SWAMY, S.D.; Hemareddy, H. Effectiveness of one cycle of phenotype-based backcross breeding for resistance to late wilt disease in maize (Zea mays L.). Mysore J. Agric. Sci. 2020, 54, 47–50. [Google Scholar]
- Galal, O.A.; Aboulila, A.A.; Motawei, A.; Galal, A. Biochemical and molecular diversity and their relationship to late wilt disease resistance in yellow maize inbred lines. Egypt. J. Genet. Cytol. 2019, 47, 203–227. [Google Scholar]
- Kamara, M.M.; Ghazy, N.A.; Mansour, E.; Elsharkawy, M.M.; Kheir, A.M.S.; Ibrahim, K.M. Molecular Genetic Diversity and Line × Tester Analysis for Resistance to Late Wilt Disease and Grain Yield in Maize. Agronomy 2021, 11, 898. [Google Scholar] [CrossRef]
- El-Shafey, H.A.; El-Shorbagy, F.A.; Khalil, I.I.; El-Assiuty, E.M. Additional sources of resistance to the late-wilt disease of maize caused by Cephalosporium maydis. Agric. Res. Rev. Egypt 1988, 66, 221–230. [Google Scholar]
- Amir, N.; Bosek, A.; Rabinovitz, O. Summary of cultivars resistance test for late wilt disease—Yavne (Israel central district) 2014. Nir Vatelem 2015, 58, 17–19. [Google Scholar]
- El-Hosary, A.; El-Fiki, I. Diallel cross analysis for earliness, yield, its components and resistance to late wilt in maize. Int. J. Agric. Sci. Res. 2015, 5, 199–210. [Google Scholar]
- Sunitha, N.; Gangappa, E.; Gowda, R.V.; Ramesh, S.; Biradar, S.; Swamy, D.; Hemareddy, H. Discovery of Genomic Regions Associated with Resistance to Late Wilt Disease Caused by Harpophora Maydis (Samra, Sabet and Hing) in Maize (Zea mays L.). J. Appl. Genet. 2021. [Google Scholar] [CrossRef]
- Al Taweel, H. Mapping of QTLs for Resistance to Late Wilt of Maize in Egypt Using SNP; The American University in Cairo Digital Archive and Research Repository (DAR Repository): New Cairo, Egypt, 2013; Available online: http://dar.aucegypt.edu/handle/10526/3595 (accessed on 30 November 2021).
- Ghazy, N.; El-Gremi, S.; Belal, E.-S. Chemical and Histological Differences of Corn (Zea mays L.) Responsive to Harpophora maydis Infection. Environ. Biodivers. Soil Secur. 2017, 1, 3–7. [Google Scholar] [CrossRef]
- Nicholson, R.L.; Hammerschmidt, R. Phenolic compounds and their role in disease resistance. Annu. Rev. Phytopathol. 1992, 30, 369–389. [Google Scholar] [CrossRef]
- Nazim, M.; El-Assiuty, E.; El-Shennawy, Z.; El-Shanawani, M.; Zein El-Abedeen, A. Source of variation in Cephalosporium maydis; the causal of late wilt of maize. 4Th. In Proceedings of the International Mycological Congress (Imc4), Regensburg, Germany, 28 August–3 September 1990. [Google Scholar]
- Sadik, E. Studies on Cephalosporium maydis the Incitant of Late Wilt of Maize. Master’s Thesis, Faculty of Agriculture, Assiut University, Assiut, Egypt, 1973. [Google Scholar]
- Rushdi, M.; Sadik, E. Studies on the nature of resistance in maize [Keystone 203 inbred, DC 67 hybrid varieties] to Cephalosporium maydis infection. Assiut J. Agric. Sci. 1975, 6, 69–76. [Google Scholar]
- Abd El-Ghani, H. Studies on Stalk Rot Disease of Corn in Egypt. Ph.D. Thesis, Faculty of Agriculture, Ain Shams Univresity, Cairo, Egypt, 1987. [Google Scholar]
- Fadle, F. Studies on Some Factors Affecting Late Wilt and Black Bundle Disease of Maize in UAR. Ph.D. Thesis, Faculty of Agriculture, Ain Shams Univresity, Cairo, Egypt, 1968. [Google Scholar]
- Degani, O.; Goldblat, Y. Potential Role of Laccases in the Relationship of the Maize Late Wilt Causal Agent, Magnaporthiopsis maydis, and Its Host. J. Fungi 2020, 6, 63. [Google Scholar] [CrossRef] [PubMed]
- Saeed, F.; Abou-Elseoud, M.; Darwish, A. Anatomical structure of corn roots in relation to their resistance to late wilt disease. Assiut J. Agric. Sci. 1990, 21, 179–191. [Google Scholar]
- Singh, S.D.; Siradhana, B.S. Date of sowing in relation to late wilt disease of maize. Indian Phytopathol. 1988, 41, 489–491. [Google Scholar]
- Bari, R.; Jones, J.D. Role of plant hormones in plant defence responses. Plant Mol. Biol. 2009, 69, 473–488. [Google Scholar] [CrossRef] [PubMed]
- Degani, O.; Drori, R.; Goldblat, Y. Plant growth hormones suppress the development of Harpophora maydis, the cause of late wilt in maize. Physiol. Mol. Biol. Plants 2015, 21, 137–149. [Google Scholar] [CrossRef] [Green Version]
- Awad, A.M.; El-Abbasi, I.H.; Shoala, T.; Youssef, S.A.; Shaheen, D.; Amer, G.A.E.-A. PCR and Nanotechnology Unraveling Detection Problems of the Seed-borne Pathogen Cephalosporium maydis, the Causal Agent of Late Wilt Disease in Maize. Int. J. Nanotechnol. Allied Sci. 2019, 3, 30–39. [Google Scholar]
- Campos, M.D.; Patanita, M.; Campos, C.; Materatski, P.; Varanda, C.M.; Brito, I.; Félix, M.d.R. Detection and Quantification of Fusarium spp. (F. oxysporum, F. verticillioides, F. graminearum) and Magnaporthiopsis maydis in Maize Using Real-Time PCR Targeting the ITS Region. Agronomy 2019, 9, 45. [Google Scholar] [CrossRef] [Green Version]
- Magarey, R.D.; Borchert, D.M.; Engle, J.S.; Colunga-Garcia, M.; Koch, F.H.; Yemshanov, D. Risk maps for targeting exotic plant pest detection programs in the United States. EPPO Bull. 2011, 41, 46–56. [Google Scholar] [CrossRef] [Green Version]
- El-Shabrawy, E.-S.; Shehata, H. Controlling maize late-wilt and enhancing plant salinity tolerance by some rhizobacterial strains. Egypt. J. Phytopathol. 2018, 46, 235–255. [Google Scholar] [CrossRef]
- Hamza, A.M.; El-Kot, G.; El-Moghazy, S. Non-traditional methods for controlling maize late wilt disease caused by Cephalosporium maydis. Egypt. J. Biol. Pest Control 2013, 23, 87–93. [Google Scholar]
- Khokhar, M.K.; Hooda, K.S.; Sharma, S.S.; Singh, V. Post flowering stalk rot complex of maize-Present status and future prospects. Maydica 2014, 59, 226–242. [Google Scholar]
- Degani, O.; Kalman, B. Assessment of Commercial Fungicides against Onion (Allium cepa) Basal Rot Disease Caused by Fusarium oxysporum f. sp. cepae and Fusarium acutatum. J. Fungi 2021, 7, 235. [Google Scholar] [CrossRef] [PubMed]
- Begum, H.; Mohammad, S.; Rao, G.K.; Raj, R.B. Influence of seed dressing fungicides on the incidence of post flowering stalk rot (late wilt and charcoal rot), yield and profitability of maize. Crop Res. Hisar 1989, 2, 142–146. [Google Scholar]
- Satyanarayana, E.; Begum, H. Relative efficacy of fungicides (seed dressers) and irrigation schedule for the control of late wilt of maize. Curr. Res. Univ. Agric. Sci. Bangalore 1996, 25, 59–60. [Google Scholar]
- Sabet, K.A.; Samra, A.S.; Abdel-Rahim, M.F. Systemic action of benomyl against late-wilt disease of maize. Ann. Appl. Biol. 1972, 71, 211–218. [Google Scholar] [CrossRef]
- Ashour, A.; Sabet, K.; El-Shabrawy, E.-S.; Alhanshoul, A. Control of maize late wilt and enhancing plant growth parameters using rhizobacteria and organic compounds. Egypt. J. Phytopathol. 2013, 41, 187–207. [Google Scholar] [CrossRef]
- Singh, S.D.; Siradhana, B.S. Chemical control of late wilt of maize induced by Cephalosporium maydis. Indian J. Mycol. Plant Path. 1989, 19, 121–122. [Google Scholar]
- Fernández-Ortuño, D.; Torés, J.A.; De Vicente, A.; Pérez-García, A. Mechanisms of resistance to QoI fungicides in phytopathogenic fungi. Int. Microbiol. 2010, 11, 1–9. [Google Scholar]
- Avila-Adame, C.; Koller, W. Characterization of spontaneous mutants of Magnaporthe grisea expressing stable resistance to the Qo-inhibiting fungicide azoxystrobin. Curr. Genet. 2003, 42, 332–338. [Google Scholar] [CrossRef]
- Fungicide Resistance Action Committee. List of Plant Pathogenic Organisms Resistant to Disease Control Agents. Available online: https://www.frac.info/docs/default-source/working-groups/sdhi-fungicides/group/list-of-resistant-plant-pathogens_2012-edition.pdf (accessed on 30 November 2021).
- Gisi, U.; Sierotzki, H.; Cook, A.; McCaffery, A. Mechanisms influencing the evolution of resistance to Qo inhibitor fungicides. Pest Manag. Sci. 2002, 58, 859–867. [Google Scholar] [CrossRef]
- Castroagudín, V.L.; Ceresini, P.C.; de Oliveira, S.C.; Reges, J.T.; Maciel, J.L.; Bonato, A.L.; Dorigan, A.F.; McDonald, B.A. Resistance to QoI fungicides is widespread in Brazilian populations of the wheat blast pathogen Magnaporthe oryzae. Phytopathology 2015, 105, 284–294. [Google Scholar] [CrossRef] [PubMed] [Green Version]
- El-Moghazy, S.; Shalaby, M.E.; Mehesen, A.A.; Elbagory, M. Fungicidal effect of some promising agents in controlling maize late wilt disease and their potentials in developing yield productivity. Environ. Biodivers. Soil Secur. 2017, 1, 129–143. [Google Scholar] [CrossRef]
- Doleib, N.M.; Farfour, S.A.; Al-shakankery, F.M.; Ammar, M.; Hamouda, R.A. Antifungal activates of cyanobacteria and some marine algae against Cephalosporium maydis, the cause of Maize Late Wilt disease In Vitro. Biosci. Res. 2021, 18, 536–543. [Google Scholar]
- El-Mehalowy, A.A.; Hassanein, N.M.; Khater, H.M.; Daram El-Din, E.A.; Youssef, Y.A. Influence of maize root colonization by rhizosphere actinomycetes and yeast fungi on plant growth and on the biological control of late wilt disease. Inter. J. Agric. Biol. 2004, 6, 599–605. [Google Scholar]
- Harman, G.E.; Howell, C.R.; Viterbo, A.; Chet, I.; Lorito, M. Trichoderma species-opportunistic, avirulent plant symbionts. Nat. Rev. Microbiol. 2004, 2, 43–56. [Google Scholar] [CrossRef]
- Harman, G.E. Overview of Mechanisms and Uses of Trichoderma spp. Phytopathology 2006, 96, 190–194. [Google Scholar] [CrossRef] [PubMed] [Green Version]
- El-Gazzar, N.; El-Bakery, A.M.; Ata, A.A. Influence of some bioagents and chitosan nanoparticles on controlling maize late wilt and improving plants characteristics. Egypt. J. Phytopathol. 2018, 46, 243–264. [Google Scholar] [CrossRef]
- Degani, O.; Dor, S. Trichoderma Biological Control to Protect Sensitive Maize Hybrids Against Late Wilt Disease in the Field. J. Fungi 2021, 7, 315. [Google Scholar] [CrossRef]
- Gal-Hemed, I.; Atanasova, L.; Komon-Zelazowska, M.; Druzhinina, I.S.; Viterbo, A.; Yarden, O. Marine isolates of Trichoderma spp. as potential halotolerant agents of biological control for arid-zone agriculture. Appl. Environ. Microbiol. 2011, 77, 5100–5109. [Google Scholar] [CrossRef] [PubMed] [Green Version]
- Degani, O.; Khatib, S.; Becher, P.; Gordani, A.; Harris, R. Trichoderma asperellum Secreted 6-Pentyl-α-Pyrone to Control Magnaporthiopsis maydis, the Maize Late Wilt Disease Agent. Biology 2021, 10, 897. [Google Scholar] [CrossRef] [PubMed]
- Degani, O.; Danielle, R.; Dor, S. The microflora of maize grains as a biological barrier against the late wilt causal agent, Magnaporthiopsis maydis. Agronomy 2021, 11, 965. [Google Scholar] [CrossRef]
- Hamrouni, R.; Molinet, J.; Dupuy, N.; Taieb, N.; Carboue, Q.; Masmoudi, A.; Roussos, S. The Effect of Aeration for 6-Pentyl-alpha-pyrone, Conidia and Lytic Enzymes Production by Trichoderma asperellum Strains Grown in Solid-State Fermentation. Waste Biomass Valorization 2020, 11, 5711–5720. [Google Scholar] [CrossRef] [Green Version]
- El-Moghazy, S.; Shalaby, M. Effects of some aqueous plant extracts and sulphur compounds on the control of maize late wilt disease caused by Cephalosporium maydis. J. Agric. Res. Tanta Univ. 2006, 32, 758–775. [Google Scholar]
- Mosa, H.; Motawei, A.; El-Aal, A.A. Nitrogen fertilization influence on combining ability for grain yield and resistance to late wilt disease in maize. J. Agric. Res. Kafrelsheikh Univ. 2010, 36, 278–291. [Google Scholar]
- Sabet, K.A.; Samra, A.S.; Mansour, I.M. Saprophytic behaviour of Cephalosporium maydis and C. acremonium. Ann. Appl. Biol. 1970, 66, 265–271. [Google Scholar] [CrossRef]
- Brígido, C.; van Tuinen, D.; Brito, I.; Alho, L.; Goss, M.J.; Carvalho, M. Management of the biological diversity of AM fungi by combination of host plant succession and integrity of extraradical mycelium. Soil Biol. Biochem. 2017, 112, 237–247. [Google Scholar] [CrossRef] [Green Version]
- Sharma, M.; Sudheer, S.; Usmani, Z.; Rani, R.; Gupta, P. Deciphering the omics of plant-microbe interaction: Perspectives and new insights. Curr. Genom. 2020, 21, 343–362. [Google Scholar] [CrossRef] [PubMed]
- Diagne, N.; Ngom, M.; Djighaly, P.I.; Fall, D.; Hocher, V.; Svistoonoff, S. Roles of arbuscular mycorrhizal fungi on plant growth and performance: Importance in biotic and abiotic stressed regulation. Diversity 2020, 12, 370. [Google Scholar] [CrossRef]
- El-Shafey, H.A.; Claflin, L.E. (Eds.) Late Wilt; APS Press: St. Paul, MN, USA, 1999; pp. 43–44. [Google Scholar]
- Smit, E.; Van Rensburg, G.D.J.; Rijkenberg, F. Number of isolates of maize root fungi in different crop rotation systems. S. Afr. J. Plant Soil 1997, 14, 127–130. [Google Scholar] [CrossRef]
- Galal, A.A.; El-Rouby, M.M.; Gad, A.M. Genetic analysis of resistance to late wilt (Cephalosporium maydis) in variety crosses of maize. Z. Planzenzucht. 1979, 83, 176–183. [Google Scholar]

Publisher’s Note: MDPI stays neutral with regard to jurisdictional claims in published maps and institutional affiliations. |
© 2021 by the author. Licensee MDPI, Basel, Switzerland. This article is an open access article distributed under the terms and conditions of the Creative Commons Attribution (CC BY) license (https://creativecommons.org/licenses/by/4.0/).
Share and Cite
Degani, O. Control Strategies to Cope with Late Wilt of Maize. Pathogens 2022, 11, 13. https://doi.org/10.3390/pathogens11010013
Degani O. Control Strategies to Cope with Late Wilt of Maize. Pathogens. 2022; 11(1):13. https://doi.org/10.3390/pathogens11010013
Chicago/Turabian StyleDegani, Ofir. 2022. "Control Strategies to Cope with Late Wilt of Maize" Pathogens 11, no. 1: 13. https://doi.org/10.3390/pathogens11010013
APA StyleDegani, O. (2022). Control Strategies to Cope with Late Wilt of Maize. Pathogens, 11(1), 13. https://doi.org/10.3390/pathogens11010013






